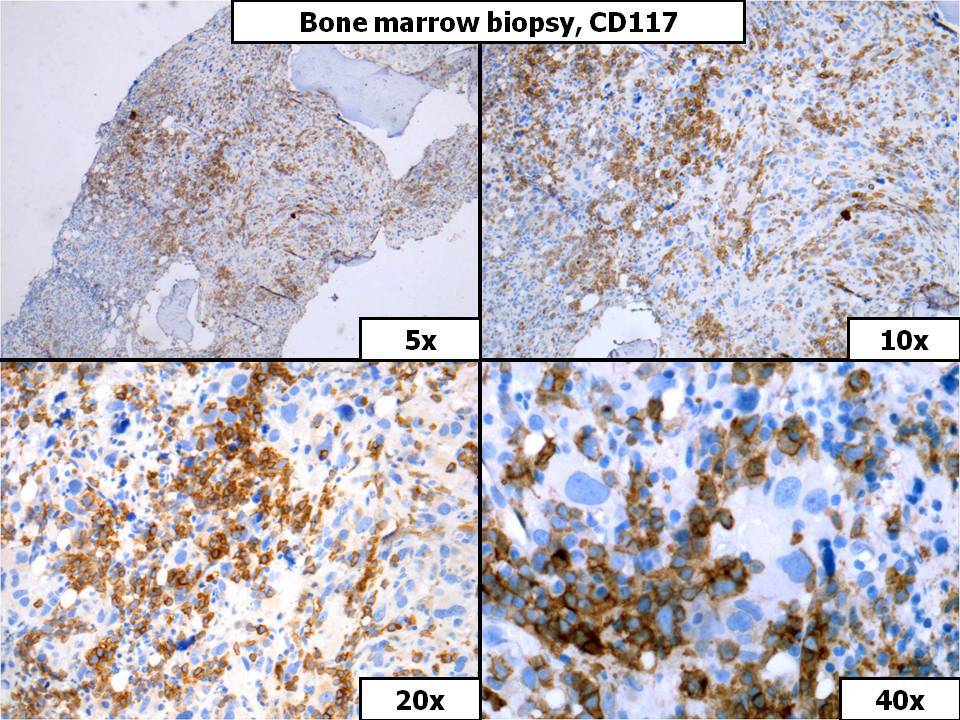
Bone Marrow Biopsy, CD117

Institution: Hospital of the University of Pennsylvania
Additional authors:Alina Delau Florea, MD Adam Bagg, MD
Session: Erythroleukemia and megakaryoblastic AML and mimics
HISTORY
An 86-year-old Cambodian woman presented with a one-month history of fatigue and was noted to be pancytopenic. A complete blood count showed a white blood cell count of 1.0 x 103/µL (no differential count available; however, there were reportedly no circulating blasts), hemoglobin of 6.3 g/dL, and platelet count of 14 x 103/µL. A CBC performed 3 years earlier was normal.
The patient underwent a bone marrow biopsy extramurally and was then referred to our medical center. Based upon the finding of a BCR-ABL1 fusion (see details below) by RT-PCR, she was initially treated with dasatinib; side effects prompted a subsequent switch to nilotinib. Three months following the bone marrow biopsy, and two months following the initiation of tyrosine kinase inhibitor therapy, the patient reported increasing left lower extremity pain. An x-ray showed a large 2.6 x 2.2 cm lytic lesion in subtrochanteric femur. The femoral lesion was subsequently biopsied.DETAILS
Bone Marrow, Iliac Crest, Formalin (glass slides submitted to workshop):
Sections show trabecular bone with variably cellular marrow which is hypercellular (80%) overall. An expansion of large blasts with open chromatin accounts for at least 30% of cellularity. In addition, there is dramatic increase in megakaryocytes, many of which are atypical and include small hypolobated forms. A reticulin stain shows a diffuse increase in fibrosis (grade 2-3 of 4 on the modified Bauermeister scale). A bone marrow aspirate was not obtained.Lytic Bone Lesion, Left Subtrochanteric Femur, Formalin (shown in PowerPoint only):Sections show fragments of bone and fibrotic tissue with histologic and immunohistochemical features similar to those noted in the original bone marrow biopsy, albeit with fewer obvious blasts. However, interpretation is somewhat compromised by prominent crush artifact.IMMUNOHISTOCHEMISTRY AND FLOW CYTOMETRY
Immunohistochemical stains on the initial bone marrow biopsy show that the blasts are predominantly positive for CD117 with minor subsets expressing CD61 and possibly also vWF. They are negative for CD3, CD5, CD10, CD20, CD34, CD43, CD79a, MPO, PAX5, and TdT. CD61 and vWF also highlight the dysplastic megakaryocytes.
CYTOGENETIC FINDINGS
Conventional metaphase cytogenetics was reportedly not performed.
Per report, FISH studies performed on the bone marrow are negative for the following anomalies: -5/5q-, -7/7q-, +8, 20q.MOLECULAR FINDINGS
Studies performed on peripheral blood are positive for an e1-a3 BCR-ABL1 fusion transcript (by qualitative RT-PCR) and negative for a JAK2 V617F mutation.
INTERESTING FEATURES
This is an usual case of apparently de novo t(9;22)/BCR-ABL1 positive acute megakaryocytic leukemia with an e1 breakpoint in the BCR gene and the development of a lytic bone lesion.
It is not possible to definitively exclude chronic myelogenous leukemia presenting in blast phase; however, the presence of an e1 breakpoint makes this consideration quite unlikely. Similarly, while the published data are limited, e1 breakpoints are rare in de novo Ph+ AMLs, with most breakpoints affecting e13/e14. Skeletal lytic lesions have been reported in a percentage of pediatric acute megakaryoblastic leukemias; however, they are considered an unusual feature in adult cases.PROPOSED DIAGNOSIS
De novo, t(9;22)/BCR-ABL1-positive (e1 BCR breakpoint) acute megakaryoblastic leukemia.
CONSENSUS GROUP: ADDITIONAL INFORMATION/STUDIES
No FISH was performed, only molecular study was performed, and only performed on a peripheral blood sample. FISH for MDS was negative. The patient received trials of desatinib, nilotinib, and imatinib but unfortubately developed severe side effects. The patient received open reduction and internal fixation, and radiation, but the patient's condition deteriorated quickly, and expired in 3 months.
CONSENSUS DIAGNOSIS
Acute myeloid leukemia with megakaryocytic differentiation versus blast phase chronic myelogenous leukemia, with BCR/ABL1 translocation (e1 BCR breakpoint)
| Bone Marrow Biopsy, H&E, 5x |  |
| Bone Marrow Biopsy, H&E |  |
| Bone Marrow Biopsy, CD61 |  |
| Bone Marrow Biopsy, CD117 | |
| Bone Marrow Biopsy, vWF |  |
| Bone Marrow Biopsy, CD34 |  |
| Lytic Lesion, H&E |  |
| Lytic Lesion, CD61 |  |
| Lytic Lesion, CD117 |  |
| Lytic Lesion, vWF |  |
| Qualitative PCR reveals an e1-a3 BCR/ABL1 fusion |  |